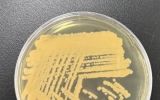

![]() 국립호남권생물자원관, 녹조 독소 분해 세균 발견
국립호남권생물자원관, 녹조 독소 분해 세균 발견[정보신문 = 김금덕 기자] 환경부 산하 국립호남권생물자원관은 녹조를 일으키는 특정 남조류 독소에 대해 우수한 분해 능력을 지닌 세균을 발굴하였다고 13일 밝혔다. 이번에 발견된 세균 ‘로도코커스 큉솅지(학명: Rhodococcus qingshengii)’는 남조류에서 분비되는 독소인 마이크로시스틴을 분해하는 특징을 갖고 있다. 마이크로시스틴은 특정 남조류가 분비하는 대표적 독소로, 인체 발암성 물질로 알려져 있다. 이 독소는 식수원으로 사용되는 강, 호수, 저수지 등 다양한 수역에서 검출되며, 해외에서는 동물 집단 ...
사회 김금덕 기자2024. 12.13![]() 광주광역시교육청, ‘학생 정치참여 교육자료’ 개발・보급
광주광역시교육청, ‘학생 정치참여 교육자료’ 개발・보급[정보신문 = 김금덕 기자] 광주시교육청(교육감 이정선)이 ‘학생 정치참여 교육 자료’를 개발해 학교에 보급한다고 13일 밝혔다. 이번 자료 개발은 학생들이 정치참여에 대한 기본적인 이해와 올바른 시민의식을 키울 수 있도록 추진됐다. 광주 학교에서의 정치참여 교육 원칙인 ▲정치적 중립성 ▲토론식 교육 ▲현장 중심 교육 ▲민주ㆍ인권ㆍ참여 증진의 교육 ▲원론적인 정치 관련 교육 원칙을 토대로 했다. 교육 자료는 교사들이 수업에 활용할 수 있도록 ‘읽기 자료’와 ‘학생 활동지’를 함께 제공하여 학교에서 학생 정치참여 교육을...
교육 김금덕 기자2024. 12.13![]() 광주시 남구, ‘자장면 쿠폰‧공모전 상금’ 등 이웃사랑 활활
광주시 남구, ‘자장면 쿠폰‧공모전 상금’ 등 이웃사랑 활활[정보신문 = 김금덕 기자] 광주 남구(구청장 김병내) 관내에서 사랑의 온기를 채우는 후원이 잇따르면서 훈훈한 감동이 이어지고 있다. 13일 남구에 따르면 무등시장 인근에서 중식당 하오를 운영하는 양수혁 대표는 최근 구청에 2만 5,000원짜리 자장면 쿠폰 200장을 기부했다. 경기 침체로 경영 여건이 녹록지 않은 상황임에도 아이들이 끼니를 거르는 일이 없도록 500만원 규모의 쿠폰을 쾌척한 것이다. 쿠폰은 관내 한 초등학교에 재학 중인 결식 우려 학생 40명에게 1인당 1장씩 먼저 쥐어졌으며, 나머지 160장은 내년...
남구 김금덕 기자2024. 12.13- 중소벤처기업부, 도전! K-스타트업 2024」왕중왕전 개최
[정보신문 = 김금덕 기자] 중소벤처기업부(장관 오영주, 이하 중기부) 광주전남지방중소벤처기업청(청장 직무대리 이순석)에 따르면, 중기부는 11(수)~12(목) 양일간 서울 코엑스에서 「도전! K-스타트업 2024」왕중왕전을 개최해 리그별 왕중왕(대상) 등 최종수상자 20팀을 선정하고 상장 20점(총 상금 15억원)을 시상했다고 밝혔다. 업력 3년 이내 기업이 참가하는 창업리그에서는 ㈜바이오브릭스가 대상을 차지하여 상금 3억원을 수상했고, 예비창업자가 참가하는 예비창업리그에서는 ㈜워터트리네즈가 대상을 수상하며 1억3천만원이 상금을 받게 됐다. ㈜바이오브릭스는 세포외기질 기반의 고부가가치 의료용 바이오잉크 소재를 개발하는 기업이며, ㈜워터트리네즈는 국제환경규제에 대응하여 불소대체용 다공성 신소재 필터를 개발하는 팀이다. 수상기업들에게는 상금과 상장 이외에도 ‘25...
경제 김금덕 기자2024. 12.13 ![]() 완도군, 2024년 청소년 정책 우수 지자체 포상 전수식 국무총리상 수상
완도군, 2024년 청소년 정책 우수 지자체 포상 전수식 국무총리상 수상[정보신문 = 김금덕 기자] 완도군이 지난 12일 서울 중구 은행회관에서 열린 여성가족부 주관 ‘2024 청소년 정책 우수 지자체 포상 전수식’에서 국무총리상을 수상했다. 이번 포상은 청소년의 건강한 성장을 지원하기 위해 청소년 활동, 보호와 복지 지원, 지역 특성을 반영한 정책 기반 강화에 노력한 지자체를 선정하여 격려하고자 마련됐다. 이날 행사에서는 먼저 청소년 정책 우수 사례를 공유하는 발표가 진행됐으며, 완도군은 ‘청소년이 빛나는 섬, 완도의 내일을 밝히다!’라는 주제로 청소년 주도 사업에 대해 발표했다. ...
완도 김금덕 기자2024. 12.13![]() 제주시, 한경유역 농업용 관정 134공 기간 연장 가결
제주시, 한경유역 농업용 관정 134공 기간 연장 가결[정보신문 = 김금덕 기자] 제주시는 올해 유효기간(5년)이 만료되는 한경유역 공공 농업용 지하수 관정 134공의 기간 연장이 가결됐다고 밝혔다. 지난 2월부터 한경유역 농업용 관정 134공을 대상으로 진행된 영향조사를 완료하여 道 지하수분과위원회의 지하수개발․이용시설 연장허가 심사에서 조건부 가결됐다. 총사업비 15억 원이 투입된 이번 조사를 통해 농업용 지하수 관정 134공 주변으로 영향범위 및 포획구간 예측 분석을 통한 지하수의 고갈과 오염을 예측하고, 「지하수개발․이용시설 취수 허가량 현행화 ...
제주시 김금덕 기자2024. 12.13![]() 제주시, 2025년 수산자원보호 직불제 사업 신청접수 연장
제주시, 2025년 수산자원보호 직불제 사업 신청접수 연장[정보신문 = 김금덕 기자] 제주시는 2025년 수산자원 보호 직접지불금(이하 직불금) 신청·접수 기간을 당초 12월 13일에서 오는 12월 20일까지로 연장한다. 이번 사업은 총허용어획량(TAC) 준수와 자율적 휴어 등 수산자원 보호를 위해 노력하는 어업인을 대상으로 직불금을 지원하는 사업이다. 직불금을 지급받고자 하는 어업인 등은 근해어업은 10척 이상, 연안어업은 20척 이상으로 단체를 구성하여 신청서와 함께 어획량 준수, 자율적 휴어 등 수산자원 보호 이행계획서를 작성해 기한 내 제출하면 된다. 단, 수산자원관리...
제주시 김금덕 기자2024. 12.13![]() 제주시, 2025년 축산분야 ICT융복합 확산사업 조기 추진
제주시, 2025년 축산분야 ICT융복합 확산사업 조기 추진[정보신문 = 김금덕 기자] 제주시는 사업비 14억 2,200만 원을 투입하여 스마트 축산농장 확대를 위한 ‘25년도 축산분야 ICT융복합 확산 지원사업을 조기 추진한다. 이번 사업은 축사 내외부에 ICT*기술을 접목시킨 자동 온도조절 장비 및 CCTV, 로봇착유기, 자동급이기, 냉방기, 축사모니터링 시스템 등을 설치하여 최적의 사양관리로 생산비를 절감하는 스마트 축사 조성을 지원하는 사업이다. 지원 대상은 한우·양돈·양계·오리·사슴·곤충·양봉·말·염소 사육농가이다. 본 사업의 특성상 사업자 선정까지 사전컨설팅, 선정위원...
제주시 김금덕 기자2024. 12.13![]() 제주도소통협력센터, 지속가능한 자립 안전망 구축 위한 세미나 및 협약식 진행
제주도소통협력센터, 지속가능한 자립 안전망 구축 위한 세미나 및 협약식 진행[정보신문 = 김금덕 기자] 제주특별자치도 소통협력센터(센터장 민복기)는 지난 9일 2024년 제주지역문제해결플랫폼의 일환으로 추진되어 온 자립지원대상 일자리 창출 관련 지속가능한 자립 안전망 구축을 위한 세미나 및 업무협약을 진행했다고 밝혔다. 사업에서는 자립준비청년, 가정 밖 및 학교 밖 청소년 등 초기 사회인으로 자립하기 위하여 주거·일자리·건강·네트워크와 같은 사회적 지원이 필요한 후기 청소년(만 18-24세)을 자립 지원대상으로 정의하고, 도내 청소년·청년 관련 기관, 중간지원조직, 취·창업 연계 가능 기관 등 총...
사회 김금덕 기자2024. 12.13![]() 제주시, 인공지능 활용 도로파손 탐지 및 분석 시스템 구축
제주시, 인공지능 활용 도로파손 탐지 및 분석 시스템 구축[정보신문 = 김금덕 기자] 제주시는 지난 9월부터 「인공지능(AI)를 활용한 도로파손 탐지 및 분석 시스템 구축 용역」을 추진 중에 있다. 본 시스템은 첨단기술을 도입하여 포트홀, 균열 등 도로 파손 현황을 실시간으로 모니터링할 수 있는 도로 환경 데이터를 구축하기 위해 도내 최초로 실시된다. 오는 16일 시범사업의 일환으로 일부 관용차량에 제주형 도로망 데이터베이스가 적용된 데이터 단말기를 부착하여 가동한 후 본격 운영에 들어간다. 시범사업 기간 동안 분석 시스템을 점검하고, 실효성을 살펴 향후 사업 확대 여부를 검토...
제주시 김금덕 기자2024. 12.13![]() 제주시, 건축공사장 안전관리 사례집 자체 제작·배부
제주시, 건축공사장 안전관리 사례집 자체 제작·배부[정보신문 = 김금덕 기자] 제주시는 관내 건설현장 안전점검에서 지적된 사례를 중심으로「건축공사장 안전관리 사례집」안내 책자를 자체 제작하여 배포한다. 안전관리 사례집은 2023~2024년 동안 민·관 합동으로 실시한 취약시기 대비 건축·해체공사장 안전점검 시 미흡하였던 지적사례를 바탕으로「산업안전보건기준에 관한 규칙」에 근거하여 각 항목 안전 수칙을 알기 쉽게 정리하였으며, 이를 통해 현장에서 사고예방을 점검할 수 있는 기반이 마련될 예정이다. 주요 내용으로는 ▲시공·품질관리분야, ▲안전관리분야, ▲위험물·건설장비관리분...
제주시 김금덕 기자2024. 12.13![]() 제주시, 개인하수처리시설 관련 업체 점검 실시
제주시, 개인하수처리시설 관련 업체 점검 실시[정보신문 = 김금덕 기자] 제주시는 2024년 개인하수처리시설 관련 업체 22개소의 운영실태를 점검한 결과 관련법을 위반한 사업장 3곳을 적발했다. 이번 점검은 개인하수처리시설 관련업 지도점검 계획에 따라 개인하수처리시설 관련 업체의 적정 운영과 환경의식 고취를 목표로 실시했으며, 설계‧시공업체 9개소, 제조업체 1개소, 관리업체 12개소에 대하여 점검한 결과 하수도법을 위반한 사업장 3곳을 적발했다. 주요 점검 사항은 ▲시설‧장비 및 기술인력 등 등록기준 준수 여부, ▲개인하수처리시설 관련 영업...
제주시 김금덕 기자2024. 12.13- 군산시, 지역자율형 사회서비스 투자사업 최우수상 수상
[정보신문 = 김금덕 기자] 13일 군산시는 전북특별자치도에서 주관하는 ‘2024년 지역자율형 사회서비스 투자사업 시․군 성과평가’에서 최우수상을 수상하였다고 밝혔다. 이로써, 군산시는 2021년 최우수, 2022년 우수, 2023년 최우수 기관 선정에 이어 올해도 최우수 기관에 선정됨으로써 4년 연속 수상의 쾌거를 이뤄냈다. ‘지역자율형 사회서비스 투자사업’은 지역 특성에 맞는 사회서비스를 발굴하여 지역주민들에게 제공하는 사업으로, 지자체의 사업 관리 및 발굴 노력 등에 따라 사업 효과가 달라져 이 상의 의미는 더욱 크다고 할 수 있다. 그 동안 군산시는 사각지대에 놓인 대상자 발굴뿐만 아니라 중·장년 1인가구 및 가족돌봄 청년을 위한 일상 돌봄서비스 사업, 초등 돌봄서비스 학습지원 사업 등의 신규사업을 추진하였으며, 모든 제공기관에 대한 현장 조사...
군산 김금덕 기자2024. 12.13 ![]() 군산시, 2025년 중3 진로 탐색 길잡이(멘토링)동계캠프 참여자 모집
군산시, 2025년 중3 진로 탐색 길잡이(멘토링)동계캠프 참여자 모집[정보신문 = 김금덕 기자] 군산시와 군산교육발전진흥재단은 중학교 3학년 학생들을 대상으로‘2025년 중3 진로 탐색 길잡이(멘토링) 동계캠프’를 운영한다고 밝혔다. 이번 캠프는 학생들이 자신의 진로를 탐구하고 학습 동기를 고취할 수 있도록 돕기 위해 마련되었으며, 내년 1월 13일부터 17일까지 군산대학교 인문대학에서 1기와 2기로 나뉘어 진행된다. 특히, 군산시 출신 주요 대학 재학생들이 함께 참여해 학습과 진로에 대한 개별적 상담을 제공하며, 인공지능(AI)기반 진로 탐색과 4차산업 프로그램 체험을 포함한 흥미로운...
군산 김금덕 기자2024. 12.13- 군산시, ‘어린이·청소년의회’ 수료식 개최
[정보신문 = 김금덕 기자] 군산시는 14일(토) 제9기 군산시 어린이·청소년의회 수료식을 개최했다고 밝혔다. 올해로 제9기를 맞는 군산시 어린이·청소년의회는 어린이와 청소년의 권리를 보장하기 위한 의제를 발굴하고 제안하는 활동을 추진해왔으며, 이번 수료식은 어린이·청소년의원, 학부모, 내빈 등이 참석한 가운데 올해 활동을 되돌아보고 노고를 격려하는 자리였다. 이날 행사에서는 ▲제9기 어린이·청소년의회 연간 활동영상 시청, ▲지난 하반기 정례회 가결안건 반영에 대한 부서검토 결과를 포함한 경과보고, ▲수료증 수여, ▲의회 활동 우수자 표창 순으로 진행되었다. 지난 11월 ‘아동권리가 실현되는 군산’을 주제로 실시한 2024년 어린이·청소년 정책제안대회 입상자 시상도 함께 이루어졌다. 강임준 군산시장은 “어린이·청소년의원들과 제안대회 참여자들이 자신과 관련된 정책...
군산 김금덕 기자2024. 12.13
![]()
- 1
전라남도, 구례 섬진강 케이블카 설치사업 기공식 개최
![]()
- 2
제주한라대학교 RISE 사업단, ‘2025년도 RISE사업 성과공유회’ 개최
![]()
- 3
제주소방서노형119센터, 노형의용소방대와 유진단기거주시설에 생필품 및 주방 식료품 전달
![]()
- 4
제주특별자치도, 2026년도 상반기 전기차 보급사업 시작
![]()
- 5
제주특별자치도, 제주문화예술재단 청사 이전식 개최
![]()
- 6
제주특별자치도, ‘자전거 타기 좋은 제주’ 조성을 위한 민관 합동회의 개최
![]()
- 7
순천소방서 삼산여성의용소방대, 설 나눔 이웃돕기 나눔 활동 진행
![]()
- 8
전북특별자치도, 전북 지역특화형 비자, 외국인 근로자 유입으로 지역경제 활력
![]()
- 9
전북특별자치도, 겨울철 대형 화재 예방위한 위험물 사헙장 합동점검 실시
![]()
- 10
전북특별자치도, 2026년 제1차 전북지역 고용아카데미 개최
![]()
제주SK FC, 일본 가고시마 전지훈련 성료
![]()
제주SK FC, 2026시즌 선수단 등번호 공개
![]()
제주서부경찰서, 애월항에서 대형화물차 법규위반 등 특별단속 실시
![]()
제주 도평초등학교, 두드림에듀와 ‘스마트 바둑 선도학교’ 업무협약 체결
![]()
서귀포시, 지역사회서비스 투자사업 신청하세요!
![]()
서귀포시 도서관운영사무소, 연중 도서 전시‘겹겹의 제주’시작
![]()
서귀포시, 시민 대상 정보화&디지털 역량강화 교육 추진
![]()
서귀포시, 2026년 공직자 정신건강 증진사업 확대 운영
![]()
서귀포시, 행복강연과 청국장 신화의 주인공 황창연 신부의 서귀포 만감류 응원
![]()
서귀포시 공무원 노조, ‘만감류 농가 살리고 조합원 웃고’
 2026.02.08 (일) 14:20
2026.02.08 (일) 14:20